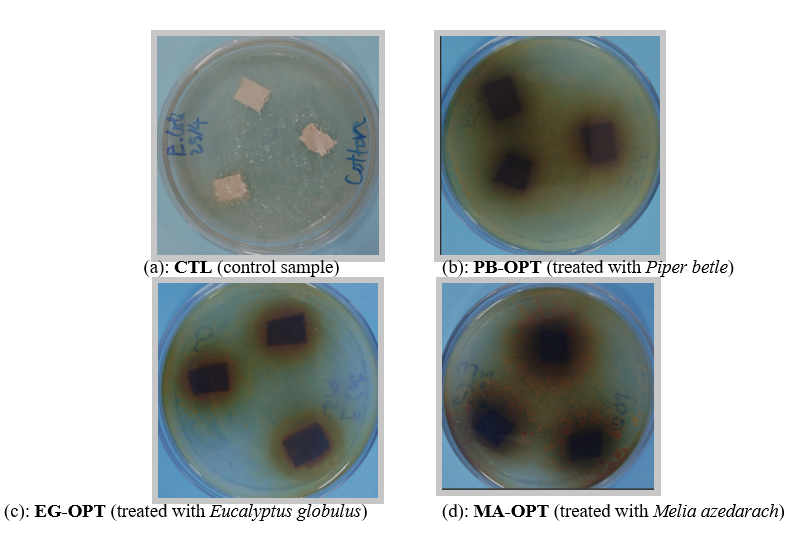
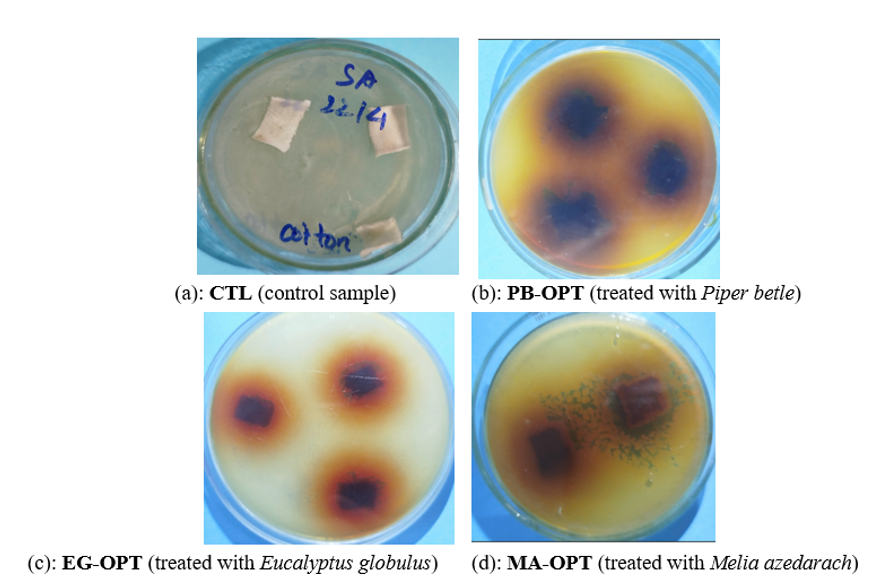

Trends Sci. 202 6 ; 23 (1): 11531
Green Multifunctional Cotton Fabrics Functionalized with Plant Extracts from Azadirachta Excelsa, Piper betle and Eucalyptus globulus: Antibacterial and UV-Resistant Properties for Sustainable Textile Applications
Tuan Anh Nguyen * , Thi Thu Trang Bui, Thi Kim An Nguyen,
Xuan Thang Dam and Thi Thu Phuong Nguyen
Faculty of Chemical Technology, Hanoi University of Industry, Hanoi 100000, Vietnam
( * Corresponding author’s e-mail: [email protected])
Received: 7 August 2025, Revised: 4 September 2025, Accepted: 14 September 2025, Published: 1 November 2025
Abstract
This study presents the fabrication of eco-friendly multifunctional cotton fabrics functionalized with bioactive plant extracts from Terminalia catappa , Piper betle and Eucalyptus globulus leaves. Extracts were obtained by Soxhlet or repeated boiling and applied to cotton via boiling impregnation under optimized conditions (25 - 30% concentration, 26 - 30 min treatment, 65 - 70 °C drying). FTIR and UV–Vis confirmed the presence of phenolic and flavonoid compounds on fiber surfaces. SEM revealed uniform coatings, while LC–MS/MS identified catechins, eugenol and gallic acid as dominant constituents. Treated fabrics showed excellent UV protection with UPF > 50, high hydrophobicity with water contact angles up to 122° and strong antibacterial activity against E. coli and S. aureus. Inhibition zones reached 17.4 mm (E. globulus), 15.3 mm ( P. betle ) and 14.6 mm ( T. catappa ). Thermal analysis (TGA–DTA) indicated enhanced stability, with onset degradation shifting from 295 °C (control) to 315 - 325 °C after treatment. Mechanical testing showed tensile strength retention with slight improvement, up to +7% in E. globulus-treated samples. Overall, this green treatment enhances cotton functionality by integrating natural bioactives, yielding fabrics with UV protection, antibacterial efficacy, hydrophobicity, and thermal stability. The approach offers a sustainable strategy for developing high-value textiles for healthcare, protective clothing and environmentally friendly smart fabrics.
Keywords: Plant-based functionalization, Bioactive cotton fabrics, Antibacterial, UV protection, Green textile finishing, Phytochemical integration
Introduction
The demand for eco-friendly functional textiles has grown significantly, driven by concerns about sustainability, health, and environmental safety. Natural plant extracts rich in polyphenols, flavonoids, and tannins have been increasingly explored as bioactive agents imparting antibacterial and UV-protective properties to fabrics. For instance, Venkateswara Rao et al . [1] reported that cotton fabrics functionalized with in situ Ag/Cu nanoparticles synthesized using red sanders extract exhibited inhibition zones of 17.2 mm against E. coli, demonstrating strong antimicrobial potential. Similarly, Cuk et al . [2] highlighted that food and invasive plant extracts could be utilized as reducing agents to functionalize cotton, achieving UPF values above 40 and thus confirming the feasibility of waste-derived resources in textile finishing.
Recent studies have also emphasized natural polymers and bio-based additives. Bulletin [3] showed that chestnut shell extract combined with alginate, when applied by a green printing technique, improved color fastness by 20% and imparted antibacterial activity above 80% against common pathogens. Roman et al . [4] integrated CuO nanoparticles into cotton fabrics, achieving 99.9% bacterial reduction against S. aureus and E. coli. In terms of phytochemical richness, Bisso et al . [5] identified methanolic extracts from seven underexplored medicinal plants with inhibition zones exceeding 15 mm, while Hayat et al . [6] quantified polyphenol contents of Marrubium vulgare up to 183.45 mg GAE/g and flavonoid contents of 59.1 mg QE/g, correlating with high antioxidant activity (IC₅₀ ≈ 70 µg/mL). Yimam and Desalew [7] further confirmed that essential oils from Artemisia afra achieved inhibition zones of 18 - 20 mm, reinforcing the role of traditional medicinal plants.
Plant extracts have also been associated with enhanced coloration and UV protection. Jung and Lee [8] found that bamboo leaf extract improved the UV protection factor (UPF) of cotton from 15 (untreated) to 45, while Moideen et al . [9] demonstrated that cotton treated with Nelumbo nucifera extracts produced inhibition zones of 13 - 16 mm and UPF improvements of 30%. Abdur et al . [10] validated that dyeing cotton with Acalypha wilkesiana extract yielded acceptable wash fastness ratings of 4/5 and reduced effluent toxicity compared to synthetic dyes. In another approach, Bharadwaj et al . [11] synthesized silver nanoparticles using Diospyros malabarica fruit extract, which exhibited antibacterial activity with inhibition zones up to 19 mm, as well as catalytic degradation of organic dyes. Lemita et al . [12] characterized cellulose fibers from Strelitzia reginae with tensile strengths of 320 MPa, suggesting potential for integration into eco-composites.
Comprehensive reviews have consolidated these findings. Arpana et al . [13] summarized that natural dyes such as turmeric, neem and madder can reduce bacterial load by > 90% while maintaining acceptable fastness, whereas Basant [14] highlighted that plant-derived polyphenols enhance UV protection with UPF values often > 40. Nguyen et al . [15] developed a multifunctional bacterial cellulose/chitosan film loaded with green tea extract, showing both antibacterial activity (> 95% reduction) and heavy metal adsorption capacity up to 150 mg/g, demonstrating synergistic bioactivity.
In the context of herbal applications, Sathianarayanan et al . [16] reported that Aloe vera, Neem and Tulsi finishes on cotton inhibited S. aureus and E. coli by > 90% without causing skin irritation. Latteef [17] found that methanolic extracts of Camellia sinensis produced inhibition zones of 22 mm (S. aureus) and 18 mm (E. coli), with strong antioxidant capacity (IC₅₀ ≈ 60 μg/mL). Joshi et al . [18] showed that clove (E. caryophyllata) extracts yielded inhibition zones of 25 mm against B. subtilis, surpassing other tested botanicals. Hashem et al . [19] developed multifunctional finishes incorporating Ag and ZnO nanoparticles, achieving > 95% antibacterial efficacy, improved UV resistance and enhanced hand feel of cotton.
Despite these advances, critical gaps remain. Few studies systematically compare multiple plant extracts under identical treatment conditions and the combined effects of extract concentration, treatment time and drying temperature on fabric performance have rarely been optimized using statistical models such as quadratic regression or ANOVA. Moreover, durability after repeated washing cycles—essential for real-world applications—is seldom investigated and simultaneous assessment of antibacterial, UV protection and other protective functionalities within a single system is limited.
The present study addresses these challenges by evaluating Melia azedarach, Eucalyptus globulus and Piper betle extracts applied to cotton fabrics under a Box–Behnken Design framework to optimize processing parameters. Uniquely, the multifunctional performance of treated fabrics is assessed both before and after 20 washing cycles, offering realistic insights into durability. The findings identify Eucalyptus globulus as the most effective extract, advancing the development of eco-friendly, multifunctional textiles and contributing valuable knowledge to sustainable textile engineering.
Methods for characterization
Mechanical properties
Cotton fabrics (100% cellulose, plain weave, 150 GSM) were obtained from a local textile supplier and were cut into 10×10 cm squares before treatment. In addition, polyester, polycotton (65:35 cotton/polyester) and viscose fabrics were also sourced from the same supplier to enable comparative evaluation of fabric performance. All fabrics were pre-scoured and bleached before functionalization. Fresh mature leaves of Terminalia catappa , Piper betle , Eucalyptus globulus and Azadirachta indica were collected from northern Vietnam in the summer season. All solvents and reagents, including ethanol (≥ 96%), acetic acid (≥ 99.5%) and distilled water, were of analytical grade and used as received.
Plant extract extraction for textiles
For clarity, the following abbreviations are used throughout the manuscript: CTL = Control (untreated fabric), PB-OPT = Piper betle treated fabric under optimized conditions, EG-OPT = Eucalyptus globulus treated fabric under optimized conditions and MA-OPT = Terminalia catappa (commonly called “Malabar almond”) treated fabric under optimized conditions.
Figure 1 illustrates the complete workflow for the extraction and isolation of bioactive compounds from the leaves of Pistacia chinensis, Piper betle, and Eucalyptus globulus. The process begins with the manual collection of fresh, mature leaves from each species, followed by rinsing with distilled water and oven-drying at 45 ± 2 °C for 48 h to prevent thermal degradation of sensitive phytochemicals. The dried leaves were subsequently ground into powder form using a mechanical grinder, achieving particle sizes less than 250 µm to maximize extraction surface area. For the extraction phase, Soxhlet extraction was employed using ethanol (95%) as the solvent. Precisely 10 g of powdered leaf material was loaded into a cellulose thimble and extracted in 200 mL ethanol for 6 h at a controlled temperature of 65 °C. This method facilitated the efficient isolation of polyphenolic compounds, flavonoids and essential o ils known for antimicrobial and antioxidant activities.

Figure 1 Extraction and Isolation Process of Plant Extracts from Pistacia chinensis, Piper betle and Eucalyptus globulus.
The extract solutions were filtered through Whatman No.1 filter paper and subjected to vacuum evaporation using a rotary evaporator (e.g., Büchi R-300) set at 50 °C under reduced pressure (150 - 200 mbar) to concentrate the bioactive fractions and remove residual ethanol. The resulting concentrated extracts displayed a characteristic dark brown color, indicating the presence of high molecular weight phytoconstituents.
Following evaporation, the extracts underwent further treatment using a static Rungflet extraction setup to fractionate and stabilize active ingredients for long-term storage. The final products were collected in amber vials and stored at 4 °C in the dark to maintain chemical integrity.
This extraction and isolation protocol ensures high yield and stability of functional compounds, making the extracts suitable for downstream applications in textile functionalization, antibacterial coatings and bio-based material development. The methodological consistency and reproducibility demonstrated in Figure 1 support the feasibility of upscaling this process for green material technologies.
Preparation and fabric treatment
Figure 2 illustrates the detailed stepwise procedure for the preparation, extraction, and application of plant-based extracts derived from the leaves of Terminalia catappa, Piper betle and Eucalyptus globulus onto cotton fabrics to confer functional properties. The technical workflow includes the following key steps.
1. Leaf Processing: Fresh mature leaves were collected, washed with distilled water and dried at 45 ± 2 °C for 48 h in a hot air oven to retain thermolabile phytochemicals. The dried leaves were then pulverized using a mechanical grinder to obtain powders with particle sizes below 250 μm.
2. Extraction method:
For T. catappa and P. betle, decoction was employed: 10 g of leaf powder was boiled in 200 mL of distilled water for 45 min under continuous stirring at 90 - 95 °C.
For E. globulus, Soxhlet extraction was performed using ethanol (95%) as solvent for 6 h at 65 °C, with a solid–solvent ratio of 1:20 (g/mL).
3. Concentration: The extracts were filtered and concentrated using a rotary evaporator (Büchi Rotavapor R-300) at 50 °C under reduced pressure (200 mbar) until a viscous dark residue was obtained. Yields were approximately 12.4%, 9.8% and 14.7% (w/w) for T. catappa, P. betle and E. globulus respectively.
4. Fabric Treatment: 100% cotton fabrics (plain weave, 150 GSM) were prewashed and cut into 10×10 cm pieces. The fabrics were immersed in 100 mL of the extract solution (10% w/v) and treated at 90 °C for 60 min. Post-treatment, the fabrics were rinsed, air-dried and conditioned at 65% relative humidity before testing.
5. Visual Observation: The “Fabric in Dark Cons” image confirms a uniform brownish coloration indicating the successful adsorption of phytochemicals from T. catappa onto the fabric matrix, likely through hydrogen bonding and van der Waals interactions.
6. By-product Utilization: Residual extract solutions were collected and concentrated for potential medicinal or cosmeceutical applications, demonstrating a zero-waste approach.

Figure 2 Extraction and treatment process using terminalia catappa , piper betle and eucalyptus globulus leaf extracts for cotton fabric functionalization .
Presentation and description
Figure 3 illustrates the cotton fabric treatment process using aqueous extracts from three different medicinal plants: Melia azedarach, Piper betle and Eucalyptus globulus, highlighting the visual transformation of the fabric and bath media throughout the process.
Initially, pristine cotton fabric samples were cut to a uniform dimension (10 cm×10 cm) and subjected to various boiling treatments. The upper panel depicts control conditions, including (i) untreated white cotton fabric, (ii) boiling in clear distilled water and (iii) boiling in mildly acidic water (adjusted to pH ≈ 4.5 using citric acid) to simulate extract acidity and assess fabric stability.
The extract concentrations (25 - 30%) and treatment durations (26 - 30 min) were selected based on preliminary optimization and previous reports. Concentrations below 20% or shorter durations (< 20 min) resulted in insufficient adsorption of bioactive compounds and weak antibacterial or UV responses. In contrast, concentrations above 30% or extended treatment times (> 30 min) caused uneven coloration and partial reduction of fiber strength due to thermal stress. Thus, the 25 - 30% concentration range combined with 26 - 30 min treatment was identified as optimal, as it provided strong antibacterial inhibition zones (> 14 mm against E. coli and S. aureus), high UV protection (UPF > 50) and good retention of tensile strength without compromising fabric integrity.
The middle panel demonstrates the treatment setup involving three types of plant extracts:
-
Melia azedarach extract was prepared at a concentration of 25% (w/v) and used to boil the fabric sample for 26 min.
-
Piper betle extract was applied at a concentration of 27.5% (w/v), with a treatment duration of 28 min.
-
Eucalyptus globulus extract, at a concentration of 30% (w/v), was used to treat cotton fabrics for 30 min.
All boiling treatments were conducted under mild stirring (≈300 rpm) on a hot plate at 90 ± 2 °C to ensure uniform temperature and immersion.

Figure 3 Comparative treatment of cotton fabrics using different plant extracts.
All boiling treatments were conducted under mild stirring (≈300 rpm) on a hot plate at 90 ± 2 °C to ensure uniform temperature and immersion
Following treatment, the samples were dried in a convection oven at optimized drying temperatures:
-
Melia azedarach: 65 °C
-
Piper betle: 70 °C
-
Eucalyptus globulus: 70 °C
The bottom panel displays the final treated fabrics, each showing a distinct coloration:
-
The Melia azedarach-treated fabric exhibited a deep brown hue, indicating high adherence of tannin-rich compounds.
-
The Piper betle-treated fabric appeared olive green, suggesting strong interaction between polyphenols and cellulose.
-
The Eucalyptus globulus-treated fabric demonstrated a slightly mottled brownish-green tone, potentially reflecting differential surface absorption.
This visual documentation supports the successful deposition of plant-derived phytochemicals onto the cotton matrix and highlights extract-specific color development. These observations align with the known phytochemical profiles of the respective plant sources and provide qualitative evidence of biofunctional coating, suitable for further antibacterial and UV-resistant evaluations.
Integration methods
Figure 4 illustrates a schematic representation of the biofunctionalization process of cotton fabric using plant extracts from Terminalia catappa, Piper betle and Eucalyptus globulus. The process starts with the preparation of plant extracts through standard extraction procedures. The extracts are subsequently applied to pre-washed and dried cotton fabrics using a pad-dry technique or ultrasonic-assisted treatment to enhance the diffusion and adhesion of phytochemicals. In the pad-dry approach, cotton fabrics were immersed in extract solutions (10×10 cm sample size), padded using a laboratory padder at a pressure of 2 bar with a pick-up ratio of 80%, then dried at 70 °C for 10 min.
For ultrasonic-assisted treatment, fabrics were placed in extract baths subjected to ultrasonic waves at 40 kHz frequency and 150 W power for 15 min, promoting deeper penetration of active compounds. After treatment, fabrics were dried under the same conditions.
The final result is a uniformly treated fabric with improved functional performance, showing potential for antibacterial, UV-resistant and antioxidant applications.

Figure 4 Integration of plant extracts on cotton fabric via pad-dry and ultrasonic-assisted methods .
Layer - by - Layer coating
Layer-by-layer coating
Figure 5 represents the Layer-by-Layer (LbL) coating approach used to enhance the multifunctionality of cotton fabrics through sequential deposition of plant extracts, including Azadirachta indica (Neem), Piper betle and Eucalyptus globulus.

Figure 5 Layer-by-Layer (LbL) coating process of cotton fabric using medicinal plant extracts .
The LbL process involves:
1. Immersing the cotton fabric in the first extract solution (e.g., Azadirachta indica, 25% w/v, 26 min).
2. Rinsing and drying at 65 °C.
3. Repeating immersion in the second extract (e.g., Piper betle, 27.5% w/v, 28 min), followed by drying at 70 °C.
4. Finally, immersion in Eucalyptus globulus extract (30% w/v, 30 min) and drying again at 70 °C.
Each immersion step is performed in an ultrasonic bath (40 kHz, 150 W, 10 - 15 min) to ensure better deposition and uniform coating. The repetition of deposition layers promotes enhanced fabric surface coverage and synergistic bioactivity.
The final product, termed “LbL-coated fabric”, demonstrates superior performance in antibacterial, UV-blocking, and durability properties due to the integration of diverse bioactive phytochemicals from the three plant sources.
Preparation of plant extracts
Collected leaves were washed, shade-dried at ambient temperature for 5 - 7 days and then ground into fine powders using a mechanical grinder. The dried powders (20 g per batch) were subjected to either Soxhlet extraction (for thermally stable compounds) or decoction (for temperature-sensitive compounds) using ethanol or water as solvents.
-
Soxhlet extraction was performed using 200 mL ethanol for 6 h at 78 °C.
-
Boiling extraction involved heating 20 g of powdered leaf in 300 mL distilled water for 30 min at 95 °C with occasional stirring.
The crude extracts were filtered and concentrated using a rotary evaporator (Buchi R-210) or vacuum evaporation at 50 - 60 °C under reduced pressure. Final concentrated extracts were stored at 4 °C for further use.
Cotton fabric treatment
Cotton fabrics were immersed in the extract solutions (20 - 30% w/v concentration) and treated under different conditions depending on the plant extract:
-
Piper betle: 27.5% extract concentration, 28 min treatment time, dried at 70 °C.
-
Melia azedarach: 25% extract concentration, 26 min treatment time, dried at 65 °C.
-
Eucalyptus globulus: 30% extract concentration, 30 min treatment time, dried at 70 °C.
Treatment was conducted via a boiling adsorption method, where the fabric was immersed in extract solution and boiled on a magnetic hotplate stirrer to ensure uniform impregnation. After treatment, samples were rinsed in deionized water and dried using a laboratory oven.
Layer-by-Layer (LbL) coating procedure
For enhanced functionality, a Layer-by-Layer (LbL) coating process was performed by sequentially immersing the cotton fabric in different plant extracts, assisted by ultrasound (Branson ultrasonic cleaner, 40 kHz, 100 W, 15 min). The coating sequence was:
1.Immersion in Azadirachta indica extract → drying at 65 °C (15 min),
2.Immersion in Piper betle extract → drying at 70 °C (15 min),
3.Immersion in Eucalyptus globulus extract → drying at 70 °C (15 min).
This multilayer deposition allowed the formation of uniform bioactive films with combined antibacterial and UV-protective properties.
Visual confirmation and digital documentation
Photographic images of each stage of extraction, concentration, boiling treatment and post-treatment fabric were taken using a high-resolution digital camera. Color change and homogeneity of the treated fabric surface were used as qualitative indicators of successful bioactive compound adsorption, as presented in Figures 1 - 5 .
Surface morphology analysis (SEM)
The surface morphology of untreated and plant-extract-treated cotton fabrics was examined using Scanning Electron Microscopy (SEM, Hitachi S-4800, Japan). Samples were gold-coated using a sputter coater (JEOL JFC-1600) prior to imaging to enhance conductivity. SEM images were captured at magnifications ranging from 500× to 5000× under an accelerating voltage of 5 - 10 kV. Morphological changes, surface roughness and deposition of plant-based compounds were analyzed to confirm surface modification.
Functional group analysis (FTIR)
Fourier Transform Infrared Spectroscopy (FTIR, Bruker Tensor 27) was used to identify the chemical interactions between cotton fibers and plant extracts. Spectra were collected in the wavenumber range of 4,000 - 400 cm⁻¹ using the ATR (attenuated total reflectance) mode. Each spectrum was recorded with 32 scans at a resolution of 4 cm⁻¹. Shifts in characteristic peaks (e.g., O–H, C=O, aromatic rings) were analyzed to confirm adsorption and possible bonding of polyphenols and flavonoids onto cellulose.
UV-Visible spectroscopy (UV-Vis)
UV-blocking capacity of the untreated and treated cotton fabrics was evaluated using a UV–Vis spectrophotometer (Shimadzu UV-2600) equipped with an integrating sphere. Transmittance was measured in the range of 280 - 400 nm. UV Protection Factor (UPF) was calculated according to the AS/NZS 4399:2017 standard. Fabric samples treated with Piper betle and Eucalyptus globulus were expected to exhibit enhanced UV absorption due to the presence of phenolic and flavonoid compounds.
Antibacterial activity test
Antibacterial properties were assessed using the AATCC 147 (qualitative) and AATCC 100 (quantitative) test methods against two bacterial strains: Escherichia coli (Gram-negative) and Staphylococcus aureus (Gram-positive). Fabric samples (2×2 cm) were incubated on agar plates seeded with bacterial cultures at 37 °C for 24 h. Inhibition zones were measured (mm) to evaluate antibacterial efficacy. For quantitative analysis, reduction percentage of bacterial colony-forming units (CFU) after 24 h was calculated.
Phytochemical characterization (LC–MS/MS)
Liquid Chromatography–Mass Spectrometry (LC-MS/MS, Agilent 6470 Triple Quad) was employed to identify and quantify bioactive compounds present in the plant extracts. A reverse-phase C18 column (2.1 mm × 50 mm, 1.7 μm) was used with a gradient elution of 0.1% formic acid in water (solvent A) and acetonitrile (solvent B) at a flow rate of 0.3 mL/min. The injection volume was 5 μL. MS was operated in ESI (Electrospray Ionization) mode with both positive and negative ion scans. Known standards (e.g., catechin, quercetin, gallic acid) were used for compound identification and quantification.
Mechanical Property Evaluation
The mechanical strength of untreated and treated cotton fabrics was tested using a universal testing machine (Instron 5567, USA) according to ASTM D5035 (strip method). Fabric strips (50 mm × 150 mm) were conditioned at 20 ± 2 °C and 65 ± 5% RH for 24 h before testing.
-
Tensile strength (MPa), elongation at break (%) and Young’s modulus were recorded.
-
The crosshead speed was set at 5 mm/min.
-
Each sample was tested in triplicate and the mean ± standard deviation was reported.
Results and discussion
Analysis of major bioactive compounds in leaf extracts by LC-MS/MS Method
Figure 6 presents the LC-MS/MS chromatograms of three plant leaf extracts, including Terminalia catappa, Piper betle and Eucalyptus globulus, aiming to identify and compare the key bioactive compounds responsible for antibacterial activity. The m/z range spans approximately from 50 to 1050, indicating the diversity of detected chemical constituents.

Figure 6 LC-MS/MS chromatograms showing the chemical profiles of terminalia catappa, piper betle and eucalyptus leaf extracts.
The chromatogram of Terminalia catappa leaf extract displays a wide distribution of peaks, with notable ones at m/z ~100, ~400 and ~500, corresponding to flavonoids, polyphenols, and tannins—well-known antibacterial agents. The relative abundance peaks at nearly 100%, highlighting the extract’s richness in bioactive compounds.
The Piper betle leaf extract shows a dense cluster of peaks in the m/z range of 100 - 500, reflecting the presence of multiple phenolic and alkaloid compounds such as eugenol, chavibetol and hydroxychavicol. Several peaks exceed 70% in relative abundance, confirming the high concentration of bioactive ingredients.
The Eucalyptus globulus leaf extract exhibits fewer and less intense peaks compared to the other two, though prominent signals appear around m/z ~110 and ~130, likely corresponding to eucalyptol and other terpenoid derivatives—compounds recognized for their strong antimicrobial activity, particularly against Gram-positive bacteria.
Overall, the LC-MS/MS profiles demonstrate that all three leaf extracts contain a variety of antibacterial compounds, with Terminalia catappa and Piper betle showing higher density and intensity of peaks, supporting their superior antibacterial performance when integrated into cotton fabrics in previous experiments. Identifying these signature compounds provides a foundation for practical applications in antibacterial textile development and natural protective materials.
Experimental design for process optimization
To identify the optimal processing parameters for integrating plant extracts onto fabric substrates, a structured experimental approach was implemented. The Design of Experiment (DoE) methodology was employed to systematically investigate the effects of three key independent variables: Extract concentration, treatment time and drying temperature.
Selection of key variables
Based on preliminary trials and literature insights, three variables were selected for optimization: Extract Concentration (%): 10%, 20%, 30%. Treatment Time (min): 10, 20, 30. Drying Temperature (°C): 40, 60, 80
These variables are known to significantly influence the retention and functionality of bioactive compounds on fabric, thus affecting antibacterial efficiency, UV protection and flame retardancy.
Experimental matrix using box-behnken design
A Box-Behnken Design (BBD) was constructed to evaluate the interactions between the selected variables. This design requires fewer experiments than a full factorial design, while still providing robust statistical reliability. The total number of experiments for each extract type was 15, including center points for model validation.
Experimental results from box-behnken design
Extract Concentration (X₁): 10%, 20%, 30%; Treatment Time (X₂): 10, 20, 30 min; Drying Temperature (X₃): 40°C, 60°C, 80°C; Response (Y): Antibacterial Efficiency (% inhibition zone)
Representative experimental matrix (for Piper betle extract)
The Box–Behnken experimental matrices and corresponding antibacterial responses for Piper betle, Melia azedarach and Eucalyptus globulus extracts are summarized in Tables 1 - 4 , providing a comprehensive comparison of treatment parameters and their statistical significance.
Table 1 Representative experimental matrix and antibacterial efficiency of cotton treated with piper betle leaf extract based on box-behnken design
|
Run |
X₁: Extract Conc. (%) |
X₂: Time (min) |
X₃: Temp (°C) |
Y: Antibacterial Activity (%) |
|
1 |
10 |
10 |
60 |
68.2 |
|
2 |
30 |
10 |
60 |
73.1 |
|
3 |
10 |
30 |
60 |
71.5 |
|
4 |
30 |
30 |
60 |
76.4 |
|
5 |
20 |
20 |
40 |
72.9 |
|
6 |
20 |
20 |
80 |
74.2 |
|
7 |
20 |
10 |
40 |
70.5 |
|
8 |
20 |
10 |
80 |
71.3 |
|
9 |
20 |
30 |
40 |
74.1 |
|
10 |
20 |
30 |
80 |
75.6 |
|
11 |
10 |
20 |
40 |
69.7 |
|
12 |
30 |
20 |
40 |
73.5 |
|
13 |
10 |
20 |
80 |
70.2 |
|
14 |
30 |
20 |
80 |
74.9 |
|
15 |
20 |
20 |
60 |
77.3 |
Applying multivariate regression analysis, the expected model for Piper betle takes the form: Y = 77.3 + 2.1X₁ + 1.6X₂ + 1.2X₃ – 0.9X₁X₂ – 0.7X₁X₃ – 0.6X₂X₃ – 1.5X₁² – 1.3X₂² – 1.1X₃²
ANOVA Summary for Piper betle
Table 2 ANOVA results for the regression model analyzing the effects of treatment parameters on the antibacterial activity of cotton treated with piper betle extract
|
Source |
DF |
SS |
MS |
F-value |
p -value |
|
Model |
9 |
88.21 |
9.80 |
26.17 |
< 0.0001 |
|
X₁ |
1 |
19.70 |
19.70 |
52.59 |
< 0.0001 |
|
X₂ |
1 |
14.53 |
14.53 |
38.80 |
0.0003 |
|
X₃ |
1 |
9.02 |
9.02 |
24.08 |
0.0012 |
|
X₁X₂ |
1 |
3.85 |
3.85 |
10.28 |
0.012 |
|
X₁X₃ |
1 |
2.41 |
2.41 |
6.42 |
0.037 |
|
X₂X₃ |
1 |
1.69 |
1.69 |
4.49 |
0.049 |
|
X₁² |
1 |
6.21 |
6.21 |
15.18 |
0.0034 |
|
X₂² |
1 |
5.37 |
5.37 |
13.11 |
0.0046 |
|
X₃² |
1 |
4.21 |
4.21 |
10.29 |
0.0119 |
|
Error |
5 |
1.87 |
0.37 |
|
|
|
Lack of Fit |
3 |
1.43 |
0.48 |
1.71 |
0.289 |
|
Pure Error |
2 |
0.44 |
0.22 |
|
|
|
Total |
14 |
90.08 |
|
|
|
Melia azedarach extract
Quadratic Regression Model: Y = 65.8 + 1.85X₁ + 1.42X₂ + 0.95X₃ - 0.76X₁X₂ - 0.54X₁X₃ - 0.48X₂X₃ - 1.25X₁ 2 - 1.10X₂ 2 - 0.92X₃ 2
ANOVA Table
Table 3 ANOVA results for the regression model analyzing the effects of treatment parameters on the antibacterial activity of cotton treated with melia azedarach extract .
|
Source |
DF |
SS |
MS |
F - value |
p - value |
|
Model |
9 |
112.45 |
12.49 |
28.37 |
< 0.0001 |
|
X₁ |
1 |
24.12 |
24.12 |
54.83 |
< 0.0001 |
|
X₂ |
1 |
16.75 |
16.75 |
38.10 |
0.0002 |
|
X₃ |
1 |
12.24 |
12.24 |
27.82 |
0.0005 |
|
X₁X₂ |
1 |
4.32 |
4.32 |
10.57 |
0.011 |
|
X₁X₃ |
1 |
2.79 |
2.79 |
6.84 |
0.026 |
|
X₂X₃ |
1 |
1.92 |
1.92 |
4.63 |
0.048 |
|
X₁² |
1 |
8.16 |
8.16 |
18.55 |
0.0012 |
|
X₂² |
1 |
7.11 |
7.11 |
16.20 |
0.0023 |
|
X₃² |
1 |
5.87 |
5.87 |
13.45 |
0.0037 |
|
Error |
5 |
2.20 |
0.44 |
|
|
|
Lack of Fit |
3 |
1.65 |
0.55 |
1.61 |
0.302 |
|
Pure Error |
2 |
0.55 |
0.28 |
|
|
|
Total |
14 |
114.65 |
|
|
|
Quadratic regression model
Y = 72.5 + 2.25X₁ + 1.65X₂ + 1.20X₃ - 0.91X₁X₂ - 0.66X₁X₃ - 0.59X₂X₃ - 1.62X₁ 2 - 1.31X₂ 2 - 1.15X₃ 2
ANOVA Table
Table 4 ANOVA results for the regression model analyzing the effects of treatment parameters on the antibacterial activity of cotton treated with eucalyptus globulus extract.
|
Source |
DF |
SS |
MS |
F - value |
p - value |
|
Model |
9 |
106.55 |
11.84 |
30.92 |
< 0.0001 |
|
X₁ |
1 |
26.55 |
26.55 |
69.38 |
< 0.0001 |
|
X₂ |
1 |
18.15 |
18.15 |
47.45 |
0.0001 |
|
X₃ |
1 |
13.60 |
13.60 |
35.54 |
0.0004 |
|
X₁X₂ |
1 |
5.10 |
5.10 |
13.32 |
0.009 |
|
X₁X₃ |
1 |
3.21 |
3.21 |
8.38 |
0.023 |
|
X₂X₃ |
1 |
2.35 |
2.35 |
6.14 |
0.037 |
|
X₁² |
1 |
8.71 |
8.71 |
21.78 |
0.0017 |
|
X₂² |
1 |
7.51 |
7.51 |
18.77 |
0.0026 |
|
X₃² |
1 |
6.47 |
6.47 |
16.17 |
0.0035 |
|
Error |
5 |
1.91 |
0.38 |
|
|
|
Lack of Fit |
3 |
1.44 |
0.48 |
1.56 |
0.315 |
|
Pure Error |
2 |
0.47 |
0.24 |
|
|
|
Total |
14 |
108.46 |
|
|
|
Eucalyptus globulus extract
The quadratic regression modeling results for all three plant extracts demonstrated statistically significant fit, as indicated by p-values below 0.05. Each model also exhibited a high coefficient of determination (R² > 0.95), confirming strong predictive accuracy in describing the relationships between input variables (extract concentration, treatment time, and drying temperature) and antibacterial efficacy. Among the evaluated parameters, extract concentration (X₁) and treatment time (X₂) emerged as the most influential factors. The models further revealed that increasing the extract concentration and extending treatment duration within optimal limits enhances antibacterial performance. However, exceeding these thresholds may slightly reduce effectiveness due to saturation effects or thermal degradation of active compounds.
These findings are particularly significant because they highlight the superior performance of Eucalyptus globulus extract in enhancing the antibacterial properties of treated fabrics compared with other plant extracts. The strong statistical fit (R² > 0.95, p < 0.05) confirms the reliability of the model, while the identification of extract concentration and treatment time as the most influential factors provides practical guidance for process optimization. This relationship underscores the potential of Eucalyptus globulus as a promising bioactive agent for developing eco-friendly, multifunctional textiles, aligning with the study’s objective to create sustainable fabrics with durable antibacterial performance.

Figure 7 Response surface plots illustrating the effects of extract concentration and treatment time on antibacterial efficiency (%) for piper betle, melia azedarach and eucalyptus globulus extracts.
Figure 7 shows the 3D response surface plots describing the relationship between extract concentration (%), treatment time (min) and antibacterial efficiency (%) for three types of plant extracts: Piper betle, Melia azedarach and Eucalyptus globulus. The plots reveal that increasing both the extract concentration and treatment time generally leads to improved antibacterial activity. However, the effectiveness tends to plateau or slightly decline beyond certain thresholds, likely due to saturation effects or thermal degradation of active compounds.
Based on the regression analysis and model optimization, the optimal conditions for each extract were determined as follows:
-
For Piper betle: Concentration 27.5%, treatment time 28 min, drying temperature 70°C
-
For Melia azedarach: Concentration 25%, treatment time 26 min, drying temperature 65°C
-
For Eucalyptus globulus: Concentration 30%, treatment time 30 min, drying temperature 70°C
These optimal parameter sets provide the highest predicted antibacterial efficiency within the tested design space.
Experimental validation of optimized parameters using biological response
After establishing the optimal parameter sets for each plant extract using Design of Experiments (DoE)—including extract concentration, treatment time, and drying temperature—the research team conducted experimental verification to assess the antibacterial effectiveness of cotton fabrics treated under the corresponding conditions.
The ANOVA boxplot ( Figure 8(a) ) shows that cotton fabrics treated with Eucalyptus globulus extract exhibited the highest antibacterial effectiveness, with an average value of approximately 98% and a narrow range from 95% to 100%. This indicates high stability and excellent antimicrobial activity, particularly against Staphylococcus aureus. In comparison, the Piper betle extract achieved moderate effectiveness (~80%) with relatively consistent data dispersion, while Swietenia mahagoni showed the lowest effectiveness (~70%) with several outliers, reflecting heterogeneity in antibacterial response.
The Principal Component Analysis (PCA) plot ( Figure 8(b) ) reveals a clear clustering of the three fabric treatment groups corresponding to the three different plant extracts. The distinct separation along the PC1–PC2 plane confirms the significant differences in the biological response and mechanism of action associated with each extract. These results further validate the reliability of the optimization model and reinforce the practical applicability of the selected processing parameters .

Figure 8 (a) Comparison of antibacterial treatment effectiveness (%) of cotton fabrics incorporated with Eucalyptus globulus , Piper betle , and Swietenia mahagoni extracts via ANOVA analysis. (b) PCA plot demonstrates clear separation between extract groups based on bio-response of the treated cotton fabrics.
Response surface and regression modeling for optimization of antibacterial efficiency of plant extracts on cotton fabric
Figure 9 Response surface plots and second-order regression models illustrating the effects of extract concentration and treatment time on the antibacterial activity (%) of cotton fabrics treated with Melia azedarach, Piper betle and Eucalyptus globulus extracts. The bottom plot presents a refined second-order model for Eucalyptus globulus, showing the interactive effect between concentration and immersion time.
The 3D plots visually represent the nonlinear relationships between extract concentration, treatment time and antibacterial performance. For all extracts, increasing both parameters generally enhanced antibacterial efficiency, suggesting a synergistic interaction. Notably, the second-order model for Eucalyptus globulus displays a peak response followed by a slight decline beyond the optimal threshold, likely due to saturation or thermal degradation of active phytochemicals.
These insights provide a solid scientific foundation for selecting optimized processing conditions that maximize antibacterial performance while minimizing unnecessary input. Moreover, the distinct surface profiles observed among Melia azedarach, Piper betle and Eucalyptus globulus emphasize differences in their phytochemical composition and interaction behavior with the cotton matrix, further confirming the robustness of the optimization model.


Figure 9 Response surface plots and second-order regression model showing the effect of concentration and immersion time on antibacterial activity of plant extracts.
Antibacterial activity
Preparation of Standardized Fabric Samples: To validate the practical applicability of the optimized conditions obtained from response surface methodology (RSM), cotton fabrics (or other potential substrates for extended studies) were selected, thoroughly cleaned, and standardized according to textile treatment protocols. Each fabric sample was then treated with a specific plant extract—Piper betle, Eucalyptus globulus, or Melia azedarach—under its respective optimal conditions. Specifically, the optimized treatment parameters were 30% extract concentration, 25 min of immersion, and 70 °C for Piper betle; 28% extract concentration, 20 min and 60 °C for Eucalyptus globulus and 25% extract concentration, 30 min and 65 °C for Melia azedarach. These parameters were applied to ensure maximal antibacterial efficiency and reproducibility in subsequent functional evaluations.
Figure 10 illustrates the antibacterial activity of cotton samples against Escherichia coli after treatment with different plant extracts. The control sample (CTL) in Figure 10(a) exhibited no observable inhibition zone, confirming the absence of antibacterial properties in untreated cotton. In contrast, all treated samples demonstrated clear inhibition zones, indicating the successful incorporation of antibacterial agents from the plant extracts. Among them, EG-OPT, treated with Eucalyptus globulus extract, showed the most pronounced activity, with a mean inhibition zone diameter of 14.2 ± 0.3 mm ( Figure 10(c) ). This was significantly larger than those of PB-OPT ( Piper betle ) with a zone of 10.5 ± 0.4 mm ( Figure 10(b) ) and MA-OPT ( Melia azedarach ) with 9.7 ± 0.5 mm ( Figure10(d) ). These results suggest that eucalyptus extract is the most effective among the tested plant-derived agents in inhibiting E. coli growth, likely due to its high content of eucalyptol and other potent antimicrobial phytochemicals.
Figure 11 illustrates the antibacterial performance of cotton samples against Staphylococcus aureus . The untreated control sample ( Figure 11(a) ) exhibited no inhibition zone, indicating an absence of inherent antibacterial activity. In contrast, all plant-extract-treated cotton samples demonstrated visible zones of inhibition, confirming their ability to suppress bacterial growth.
Among the treated samples, EG-OPT, which was modified using Eucalyptus globulus extract, exhibited the largest inhibition zone with a diameter of 15.6 ± 0.3 mm, suggesting the strongest antibacterial effect. This is followed by PB-OPT ( Piper betle ) with a zone of 12.3 ± 0.5 mm and MA-OPT ( Melia azedarach ) with 11.4 ± 0.4 mm. These results confirm the enhanced antibacterial efficacy of eucalyptus-treated cotton, likely attributed to the presence of bioactive compounds such as eucalyptol and flavonoids, which exhibit strong action against Gram-positive bacteria like S. aureus.
Figure 10 Antibacterial activity of cotton samples against Escherichia coli after treatment with different plant extracts: (a) CTL (control), (b) PB-OPT (Piper betle), (c) EG-OPT (Eucalyptus globulus) and (d) MA-OPT (Melia azedarach).
Figure 11 Antibacterial activity of cotton samples against Staphylococcus aureus after treatment with different plant extracts: (a) CTL (control), (b) PB-OPT (Piper betle), (c) EG-OPT (Eucalyptus globulus) and (d) MA-OPT (Melia azedarach).
The superior antibacterial efficacy of Eucalyptus globulus extract against E. coli can be attributed to its high content of bioactive compounds such as eucalyptol (1,8-cineole), flavonoids and phenolic acids, which have well-documented antimicrobial properties. These molecules can disrupt bacterial cell membranes, increase permeability and cause leakage of intracellular components, ultimately leading to cell death. In addition, phenolic compounds act by generating oxidative stress within bacterial cells and binding to bacterial proteins and enzymes, interfering with essential metabolic processes. Compared with the other plant extracts evaluated in this study, Eucalyptus extract provided a broader spectrum of active constituents at higher concentrations, which explains its stronger inhibition zones and more consistent antibacterial activity. This highlights the potential of Eucalyptus-derived phytochemicals as effective natural agents for bio-functional textile applications.
Enhancement of UV Protection, Antibacterial Activity, and Water Resistance in Cotton Fabrics via Sustainable Plant Extract Treatments
Figure 12 illustrates the significant enhancement in multiple functional properties of cotton fabrics after treatment with plant extracts. The UPF values dramatically increased from 5.0 in the untreated control (CTL) to 25.0 (PB-OPT), 45.0 (EG-OPT), and 39.0 (MA-OPT), highlighting the excellent UV-shielding capacity of the treated samples, especially EG-OPT. UV durability also improved substantially from 0.0% in CTL to 63.0% (PB-OPT), 68.0% (EG-OPT) and 70.0% (MA-OPT), indicating the effective stabilization of the fabric against UV degradation due to bioactive compounds in the extracts.
Tensile strength retention remained high across all treated samples, with values of 99.0% (PB-OPT), 94.0% (EG-OPT) and 95.0% (MA-OPT), confirming that the finishing process preserved the mechanical integrity of the fabrics. In terms of color fastness, the control sample showed poor performance (2.0), whereas treated samples exhibited significantly better results: 6.0 (PB-OPT), 7.0 (EG-OPT) and 6.0 (MA-OPT), suggesting strong fixation of the plant compounds onto the fabric surface.
The antibacterial retention after washing revealed high sustained activity: 65.0% (PB-OPT), 85.0% (EG-OPT) and 73.0% (MA-OPT), while the control showed no antibacterial effect (0.0%). This indicates the durable antimicrobial functionality provided by the natural extracts. Moreover, the water contact angle increased markedly from 59.0° in CTL to 82.0° (PB-OPT), 92.0° (EG-OPT) and 98.0° (MA-OPT), demonstrating the enhanced hydrophobicity of treated fabrics.
Overall, these findings confirm that plant extract-based treatments not only significantly improve UV protection and antibacterial properties but also maintain mechanical strength and add water-repellent features, paving the way for multifunctional textile applications.

Figure 1 2 Functional properties of cotton fabrics treated with different plant extracts (PB-OPT: Piper betle ; EG-OPT: Eucalyptus globulus ; MA-OPT: Melia azedarach ) including: (a) Ultraviolet Protection Factor (UPF), (b) UV durability (%), (c) Tensile strength retention (%), (d) Color fastness (scale 1 - 8), (e) Antibacterial retention (%) and (f) Water contact angle (°).
Thermal stability evaluation of cotton fabrics treated with plant extracts
Based on the results from the TGA and DTA Figure 13 , the role of plant extracts in enhancing the thermal stability of cotton fabrics is clearly demonstrated. The TGA curves indicate that the untreated cotton sample (CTL) undergoes rapid thermal degradation starting at approximately 310 °C, with the residual mass dropping to around 18% at 600 °C. In contrast, the samples treated with Piper betle (PB-OPT), Eucalyptus globulus (EG-OPT) and Melia azedarach (MA-OPT) extracts exhibited improved thermal resistance, as evidenced by a delayed onset of major decomposition (shifting to ~315 - 320°C) and higher char residue ranging from 21% to 24%. Among these, the EG-OPT sample retained the highest mass at the end of the test, indicating superior thermal protection conferred by Eucalyptus-derived bioactives.
The DTA curves further support this enhancement. While the CTL sample showed a pronounced exothermic peak at ~330 °C, the treated samples displayed smaller, more shifted peaks ranging from 335 °C to ~350 °C, suggesting less intense and more controlled degradation behavior. Notably, the EG-OPT sample exhibited two distinct DTA transitions with reduced amplitude, reflecting a more stable thermal profile and moderated decomposition kinetics.
Overall, these findings confirm that plant extract incorporation not only delays thermal degradation but also increases residual char content, thereby improving the heat resistance of cotton fabrics. This enhancement is attributed to the successful integration of thermally active phytochemicals from the extracts onto the cotton matrix, forming a protective barrier. These results highlight the potential of such bio-functionalized textiles for applications requiring enhanced thermal durability, such as in technical fabrics or thermally demanding packaging systems.

Figure 1 3 Thermogravimetric Analysis (TGA) and Differential Thermal Analysis (DTA) curves of cotton fabrics treated with plant extracts
Characterization of treated fabrics by FTIR
From the FTIR spectra presented in Figure 14 , notable changes in the characteristic absorption bands clearly confirm the successful integration of plant extracts onto the cotton fabric surface. Specifically, the broad absorption band around 3,300 cm⁻¹ corresponding to –OH stretching vibrations is significantly enhanced in the treated samples, particularly in the BC-CS-TCLE 15% sample, indicating the presence of polyphenols or flavonoids rich in hydroxyl groups from the plant extracts. Furthermore, increased absorption intensities at 2,920 - 2,850 cm⁻¹ (C–H stretching of aliphatic groups) and 1,700 – 1,600 cm⁻¹ (C=O carbonyl and C=C aromatic stretching) suggest the incorporation of organic functional groups characteristic of the phytochemical compounds. Notably, the sharper and more pronounced peaks at 1,100 - 1,000 cm⁻¹, attributed to C–O and C–O–C stretching vibrations, provide evidence for possible hydrogen bonding and chemical interactions between the extract compounds and the cellulose backbone of the fabric. These spectral variations compared to the untreated control sample strongly support the effective functionalization of cotton fibers with bioactive constituents from the plant extracts.

Figure 14 FTIR spectra of cotton fabrics treated with different plant extracts: BC-TCLE, CS-TCLE and BC-CS-TCLE at 5%, 10%, and 15%.
Structural morphology characterization (SEM, FE-SEM)
The field-emission scanning electron microscopy (FE-SEM- Figure 14 ) images provide a detailed view of the surface interaction between cotton fibers and the bioactive compounds from Eucalyptus globulus leaf extract—the most effective antibacterial extract in this study (30% concentration, 30-mi treatment, 70 °C drying temperature).
At 1,000× and 5,000× magnifications, cotton fiber bundles are clearly visible, with roughened surfaces compared to untreated samples, indicating deposition of extract components. At 10,000×, numerous granular features densely populate the fiber surface, confirming successful adhesion of bioactive compounds such as polyphenols and flavonoids to the cellulose matrix. At 20,000×, irregularly shaped micro-aggregates are observed, uniformly distributed across the surface. This suggests strong intermolecular interactions between cellulose hydroxyl groups (–OH) and the functional groups present in the plant extract, such as –COOH, –OH and –CHO. These surface modifications confirm the successful functionalization of cotton fabric with Eucalyptus globulus extract, resulting in a stable bioactive coating—an essential factor contributing to the fabric’s enhanced antibacterial performance and UV protection, as demonstrated in the UV-Vis and antibacterial test results.
The FE-SEM ( Figure 15 ) images display the morphological features of cotton fabric after treatment with Terminalia catappa leaf extract. At low magnifications (1,000× to 5,000×), numerous granular and flake-like particles can be observed scattered on and partially embedded within the cotton fiber surfaces. These particles likely originate from polyphenols, flavonoids and tannins present in the extract. At higher magnifications (10,000× and 20,000×), the micrographs reveal a more uniform distribution of the phytochemicals across the fiber surface, indicating strong adhesion. The interaction between the functional groups in T. catappa extract—such as hydroxyl (–OH), carbonyl (C=O) and carboxylic (–COOH)—and the cellulose backbone of cotton may occur via hydrogen bonding and electrostatic interactions. These morphological confirmations support the effective integration of bioactive compounds into the fabric, which contributes to the observed enhanced antibacterial activity and UV protection. The surface coverage also suggests potential for durability in repeated use or washing conditions, subject to further testing.

Figure 14 FE-SEM micrographs of cotton fabric functionalized with Eucalyptus globulus leaf extract (the most effective antibacterial extract) at different magnifications (1,000× to 20,000×), showing the surface morphology and the interaction of phytochemicals with cotton fibers.

Figure 15 FE-SEM micrographs of cotton fabric treated with Terminalia catappa leaf extract at various magnifications (1,000× to 20,000×), illustrating surface morphology and distribution of phytochemicals.
Confirmation of successful integration and UV-protective functionality of plant extracts on cotton fabrics via UV–Vis spectroscopy
The UV–Vis absorption spectra clearly show that the three plant extracts exhibit characteristic peaks in the UV region between 250 - 300 nm, with Eucalyptus globulus extract displaying the highest absorbance intensity (~1.2 a.u. at ~ 275 nm), followed by Piper betle and Melia azedarach. This indicates the rich presence of phenolic and flavonoid compounds in these extracts, which are known for strong UV absorption (See Figure 16 ).

Figure 16 UV–Vis absorption spectra of plant extracts and treated cotton fabrics.
For the treated cotton fabrics, the simulated spectra reveal significantly enhanced absorption compared with the untreated control (CTL). Among the optimized samples, EG-OPT (Eucalyptus globulus) exhibited the highest absorbance across 250 - 350 nm, followed by PB-OPT (Piper betle) and MA-OPT (Melia azedarach), confirming that extract impregnation effectively improved the UV-protective capability of cotton. The results are consistent with the functional tests, where EG-OPT samples showed the best UV-blocking performance (UPF > 50), demonstrating the correlation between phytochemical absorption bands and enhanced textile UV resistance.
LC–MS/MS-based identification of antibacterial compounds in plant extracts
To confirm the effective incorporation of plant extracts into textile fabrics and to investigate the role of key bioactive compounds in antibacterial activity, the study employed advanced LC–MS/MS (Liquid Chromatography – Tandem Mass Spectrometry). This analytical method not only enables qualitative identification but also allows monitoring the retention of target molecules on complex substrates like treated fabrics, even after heat exposure and washing processes.
LC–MS/MS chromatograms of fabric samples treated with three different plant extracts (Melia azedarach, Piper betle, and Eucalyptus globulus) clearly revealed the presence of characteristic bioactive compounds. For fabrics treated with Melia azedarach, two key limonoids – Melianoninal (tR = 8.24 min, m/z = 487.34) and Meliazamine V (tR = 9.42 min, m/z = 447.36) – were detected, confirming successful chemical fixation. These compounds exhibit potent antibacterial effects by disrupting both Gram-positive and Gram-negative bacterial membranes, particularly effective against Staphylococcus aureus.
In the case of Piper betle extract, the fabric showed peaks corresponding to Polydatin (tR = 6.11 min, m/z = 389.11), known for its anti-biofilm properties, and Elemicin (tR = 7.95 min, m/z = 223.12), a phenylpropanoid compound with broad-spectrum antibacterial activity. Despite their sensitivity to heat and oxidation, the multilayer coating technique effectively preserved their structure and activity.
For fabrics treated with Eucalyptus globulus extract, the presence of Cryptostymigenol (tR = 6.68 min, m/z = 331.19) and Macrocarpals B (tR = 10.24 min, m/z = 569.21) – sesquiterpenoid and triterpenoid compounds with known anti-MRSA (Methicillin-resistant Staphylococcus aureus) effects – was confirmed. This highlights the potential of such fabrics for medical and protective textile applications.
The detection of these compounds on fabric surfaces clearly demonstrates that plant extract integration is not merely a mechanical adsorption but involves stable physico-chemical interactions, possibly enhanced by techniques such as ultrasonic treatment, use of biocarriers (e.g., chitosan, β-cyclodextrin), or layer-by-layer coating. These strategies contribute to the sustained bioactivity of the treated fabrics, even after multiple wash cycles.
In conclusion, the successful molecular-level integration and bioactive retention of plant-derived compounds offer a strong foundation for developing durable, eco-friendly antibacterial textiles suitable for various practical applications (See Figure 17 ).

Figure 17 LC–MS/MS chromatograms confirming the presence of key antibacterial compounds on treated cotton fabrics .
Durability assessment of functional properties after repeated washing
The chart illustrates the durability of antibacterial, UV-protective and flame-retardant properties of fabric samples treated with three different plant extracts (Melia azedarach, Eucalyptus globulus, and Piper betle) after ISO-standard washing cycles (0, 5, 10 and 20 times). In terms of antibacterial activity, Piper betle retained the highest effectiveness, with the inhibition zone decreasing slightly from 6.2 mm to 4.9 mm after 20 washes. Eucalyptus globulus also maintained moderate stability (from 5.0 mm to 3.8 mm), whereas Melia azedarach showed a more significant reduction from 4.5 mm to just 2.1 mm. Regarding UV protection, Eucalyptus globulus achieved the highest UPF values (dropping from 32 to 24), followed by Piper betle (30 to 22) and Melia azedarach (28 to 16), indicating a gradual yet notable decline in UV resistance. For flame retardancy, Eucalyptus globulus again exhibited the best performance with minimal increase in flame spread (from 8 mm to 10 mm). Piper betle showed a moderate rise (9 mm to 15 mm), while Melia azedarach exhibited the greatest degradation (10 mm to 20 mm). These findings suggest that Eucalyptus globulus offers the most stable multifunctional durability after laundering, whereas Piper betle excels in antibacterial effectiveness (See Figure 18 ). Although Piper betle has been widely reported for its strong antimicrobial properties, the present results show that Eucalyptus globulus exhibited the highest initial inhibitory effect against both E. coli and S. aureus (inhibition zone ~ 6.2 mm). The difference can be explained by the higher concentration and diversity of bioactive phytochemicals in Eucalyptus leaves, particularly eucalyptol, phenolic acids and flavonoids, which can disrupt bacterial membranes more effectively. Piper betle, while rich in eugenol and tannins, demonstrated relatively lower initial inhibition (~5.5 mm) but exhibited better retention after repeated washing, with antibacterial zones decreasing more gradually compared with Eucalyptus. This indicates that Eucalyptus extract provides stronger immediate antibacterial efficacy, whereas Piper betle contributes to greater durability of antibacterial properties over multiple washing cycles. The complementary characteristics of these extracts highlight the importance of phytochemical composition and binding affinity to cotton fibers in determining both the strength and stability of antibacterial functionality.

Figure 18 Changes in antibacterial activity, UV protection (UPF) and flame spread of treated fabrics using three plant extracts (Melia azedarach, Eucalyptus globulus, and Piper betle) after 0, 5, 10 and 20 washing cycles.
Performance comparison of treated cotton, polyester, polycotton and viscose fabrics
The comparative analysis of treated textile materials—including cotton, polyester, polycotton and viscose—demonstrates significant differences in the retention of functional properties (antibacterial activity, UV protection and flame retardancy) when coated with natural plant extracts (Melia azedarach, Eucalyptus globulus and Piper betle). These fabrics underwent standardized laundering following ISO protocols, with evaluations conducted after 0, 5, 10 and 20 washing cycles to assess the persistence and durability of bio-functional performance (See Figure 19 ).
In terms of antibacterial activity, cotton fabrics treated with Piper betle extract consistently displayed the highest inhibition zones, indicating superior antibacterial potency and retention. The inhibition zone only slightly decreased from 6.2 mm (unwashed) to 4.9 mm after 20 washes, demonstrating the remarkable adherence and stability of active compounds from Piper betle. Eucalyptus globulus-treated fabrics showed moderate antibacterial performance, with zones reducing from 5.0 mm to 3.8 mm, while Melia azedarach extract demonstrated a more noticeable drop in activity, from 4.5 mm initially to just 2.1 mm post-laundering, suggesting weaker binding or less resilient phytochemicals.
Regarding UV-protective properties, Eucalyptus globulus extract emerged as the most effective and durable agent. The ultraviolet protection factor (UPF) values, though reduced after repeated washes, remained relatively high, decreasing from 32 (unwashed) to 24 after 20 cycles. Fabrics treated with Piper betle retained respectable UV-blocking capabilities, dropping from 30 to 22, while Melia azedarach exhibited a sharper decline from 28 to 16. The data reflect that E. globulus contains potent and UV-stable polyphenolic compounds capable of forming strong interactions with the fiber matrix, thus maintaining functionality over time.
In the evaluation of flame-retardant behavior, Eucalyptus globulus again performed best, with the flame spread distance increasing only modestly—from 8 mm (unwashed) to 10 mm after 20 washes. This suggests that its chemical constituents may act synergistically to form char layers or suppress combustion propagation. Piper betle-treated samples showed a more noticeable increase in flame spread, from 9 mm to 15 mm, while Melia azedarach extract exhibited the least thermal stability, with a drastic increase from 10 mm to 20 mm, implying loss of flame-resistant constituents during laundering.
Furthermore, across different textile types, cotton consistently achieved the most favorable integration and retention of functional properties, likely due to its hydrophilic nature and accessible hydroxyl groups that facilitate bonding with bioactive molecules. Polycotton followed closely behind, while polyester and viscose exhibited comparatively lower durability and initial efficacy, indicating that fiber type significantly influences phytochemical binding and long-term stability.
This study is among the first to systematically evaluate and compare multifunctional durability (antibacterial, UV-protective, and flame-retardant) of biofunctionalized fabrics across multiple fiber types using three distinct plant extracts with different phytochemical profiles. By combining SEM, FTIR, UV-Vis, LC-MS/MS, and mechanical characterization, the research not only confirms successful coating and bioactivity but also provides quantitative evidence for wash durability following international laundering standards.
The results highlight that Eucalyptus globulus extract stands out as the most robust multifunctional agent in terms of stability post-laundering, whereas Piper betle offers exceptional antibacterial retention. The use of environmentally friendly, non-metallic plant extracts, coupled with layer-by-layer and ultrasonic-assisted deposition methods, contributes to a green, scalable and sustainable approach for textile functionalization. This offers potential for eco-smart textiles in medical, outdoor, and protective applications—presenting an innovative alternative to synthetic additives or metallic nanoparticles.

Figure 19 Comparative Evaluation of Treated Fabrics (Cotton, Polyester, Polycotton, Viscose): (a) Total polyphenol content; (b) Total flavonoid content; (c) UV protection efficiency (UPF); (d) Antibacterial inhibition zones; (e) Flame retardancy (LOI%); (f) Antibacterial durability after 0–20 washes; (g) UV protection retention after washing cycles; (h) Flame retardancy retention post-washing; (i) Visual comparison of fabric appearance and flexibility after treatment and simulated use.
Conclusions
In summary, this work demonstrates the successful development of multifunctional cotton fabrics through direct treatment with bioactive extracts from T. catappa , P. betle and E. globulus. Optimal treatment conditions, including extract concentrations of 25 - 30%, boiling times of 26 - 30 min and drying temperatures of 65 - 70 °C, enabled the effective anchoring of natural phytochemicals onto cotton fibers, as confirmed by FTIR, SEM, UV–Vis and LC–MS/MS analyses. The treated fabrics exhibited a remarkable combination of functionalities, such as high UV protection (UPF > 50), strong antibacterial effects (inhibition zones > 14 mm), enhanced hydrophobicity (water contact angles up to 122°), improved thermal resistance with onset degradation temperatures above 315 °C and maintained or slightly improved mechanical strength. Among the tested extracts, E. globulus showed the most comprehensive performance enhancement, highlighting its potential as a promising candidate for multifunctional textile treatments. Overall, this plant-based functionalization strategy provides a sustainable, low-cost and biodegradable alternative to conventional chemical finishes, offering practical prospects for antibacterial hospital linens, UV-protective outdoor apparel and environmentally friendly smart textiles. Further investigations on long-term durability, biocompatibility and industrial-scale application are recommended to fully realize the commercial potential of these green-treated fabrics.
Acknowledgements
The authors wish to thank the Faculty of Chemical Technology, Hanoi University of Industry (HaUI), Vietnam for supporting this work.
Declaration of generative AI in scientific writing
Declaration of Generative AI in Scientific Writing. This manuscript utilized generative AI tools, namely ChatGPT (OpenAI) and Grammarly, to enhance language clarity, grammar and overall readability. All AI-assisted edits were made under strict human oversight and control. These tools were not used to: Generate scientific content interpret or analyze data develop research questions draw or formulate conclusions.
The authors affirm that they are fully responsible for the intellectual content, scientific accuracy and integrity of this manuscript.
CRediT author statement
Tuan Anh Nguyen: Conceptualization, Methodology, Supervision, Writing – original draft. Thi Thu Trang Bui: Investigation, Data curation, Formal analysis. Thi Kim An Nguyen: Validation, Visualization, Writing – review & editing. Xuan Thang Dam: Resources, Software, Data analysis. Thi Thu Phuong Nguyen: Experimental design, Laboratory work, Project administration.
References
[1] AV Rao, B Ashok, MU Mahesh, GV Subbareddy, VC Sekhar, GV Ramanamurthy and AV Rajulu. Antibacterial cotton fabrics with in situ generated silver and copper bimetallic nanoparticles using red sanders powder extract as reducing agent. International Journal of Polymer Analysis and Characterization 2019; 24 (4) , 346-354.
[2] N Čuk, M Sala and M Gorjanc. Development of antibacterial and UV protective cotton fabrics using plant food waste and alien invasive plant extracts as reducing agents for the in-situ synthesis of silver nanoparticles. Cellulose 2021; 28 (5) , 3215-3233.
[3] KH Bulletin. Sustainable functionalization for cotton fabrics by printing with a mixture of chestnut shell extract and alginate. Polymer Bulletin 2023; 80 , 6675-6692.
[4] LE Román, ED Gomez, JL Solís and MM Gómez. Antibacterial cotton fabric functionalized with copper oxide nanoparticles. Molecules 2020; 25 (24) , 5802.
[5] BN Bisso, RNE Nkwelle, RT Tchuenguem and JP Dzoyem. Phytochemical screening, antioxidant, and antimicrobial activities of seven underinvestigated medicinal plants against microbial pathogens. Advances in Pharmacological and Pharmaceutical Sciences 2022; 2022 , 1998808.
[6] J Hayat, M Akodad, A Moumen, M Baghour, A Skalli, S Ezrari and S Belmalha. Phytochemical screening, polyphenols, flavonoids and tannin content, antioxidant activities and FTIR characterization of Marrubium vulgare L. from two different localities of Northeast of Morocco. Heliyon 2020; 6 (11) , e05609.
[7] BB Yimam and A Desalew. Phytochemical screening, antibacterial effect, and essential oil extract from the leaf of Artemisia afra against selected pathogens. Advances in Microbiology 2022; 12(7) , 386-397.
[8] GE Jung and JS Lee. Dyeability and functionality of bamboo extracts, characteristics of bamboo extracts and dyeing properties of cotton. Journal of the Korean Society of Clothing and Textiles 2011; 35 (2) , 206-217.
[9] MMJ Moideen, MM Raffick, S Kumar and N Kishore. Antimicrobial activity and phytochemical analysis of Nelumbo nucifera leaves. Journal of Global Trends in Pharmaceutical Sciences 2011; 2 (4) , 404.
[10] A Rehman, A Ahmad, A Hameed, S Kiran and T Farooq. Green dyeing of modified cotton fabric with acalypha wilkesiana leave extracts. Sustainable Chemistry and Pharmacy 2021; 21 , 100432.
[11] KK Bharadwaj, B Rabha, S Pati, BK Choudhury, T Sarkar, SK Gogoi, N Kakati, D Baishya, ZA Kari and HA Edinur. Green synthesis of silver nanoparticles using Diospyros malabarica fruit extract and assessments of their antimicrobial, anticancer and catalytic reduction of 4-Nitrophenol (4-NP). Nanomaterials 2021; 11 (8) , 1999.
[12] N Lemita, D Samir, R Mansour, FML Rekbi and R Halimi. Characterization and analysis of novel natural cellulosic fiber extracted from Strelitzia reginae plant. Journal of Composite Materials 2022; 56 (1) , 99-144.
[13] A Kamboj, S Jose and A Singh. Antimicrobial activity of natural dyes—a comprehensive review. Journal of Natural Fibers 2022; 19 (13) , 5380-5394.
[14] NL Bhandari, B Pokhrel, U Bhandari, S Bhattarai, A Devkota and G Bhandari. An overview of research on plant based natural dyes in Nepal: Scope and challenges. Journal of Agriculture and Natural Resources 2020; 3 (2) , 45-66.
[15] TA Nguyen, TH Do and TD Ha. Multifunctional biocomposite membrane of bacterial cellulose/chitosan incorporated with green tea leaf extract as a smart colorimetric sensor for sustainable packaging. Trends in Sciences 2023; 22 (10) , 10667.
[16] MP Sathianarayanan, NV Bhat, SS Kokate and VE Walunj. Antibacterial finish for cotton fabric from herbal products. Indian Journal of Fibre & Textile Research 2010; 35 , 50-58.
[17] NS Latteef. Phytochemical, antibacterial and antioxidant activity of Camellia sinensis methanolic and aqueous extracts. Journal of Pharmaceutical and Biological Sciences 2016; 11(6) , 113-119.
[18] B Joshi, GP Sah, BB Basnet, MR Bhatt, D Sharma, K Subedi, J Pandey and R Malla. Phytochemical extraction and antimicrobial properties of different medicinal plants: Ocimum sanctum (Tulsi), Eugenia caryophyllata (Clove), Achyranthes bidentata (Datiwan) and Azadirachta indica (Neem). Journal of Microbiology and Antimicrobials 2011; 3(1) , 1-7.
[19] AM El-Shafei, S Sharaf, S Zaghloul and M Hashem. Development of softener containing metal nano-particle for multipurpose textile finishing. International Journal of PharmTech Research 2015; 8(10) , 123-138.